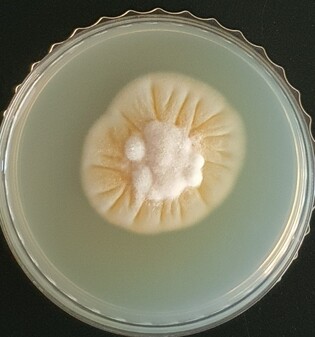
thumbimg

철원17.9℃
양평17.1℃
통영20.7℃
정읍20.0℃
김해시19.3℃
영덕18.9℃
보은18.4℃
포항18.6℃
보성군20.8℃
북부산20.8℃
성산21.6℃
북창원20.2℃
홍천15.6℃
남원19.7℃
강화17.7℃
의령군18.1℃
경주시18.7℃
속초15.2℃
백령도16.3℃
추풍령17.6℃
순창군19.8℃
울진18.4℃
강진군21.2℃
청송군19.2℃
거창18.1℃
원주17.8℃
진주19.0℃
영월17.2℃
서귀포22.3℃
태백15.4℃
장수19.1℃
북춘천14.1℃
구미18.2℃
청주20.1℃
진도군20.7℃
해남21.1℃
보령20.2℃
충주17.8℃
고산21.7℃
대관령13.1℃
세종18.1℃
합천18.2℃
천안18.2℃
울산18.5℃
대전18.9℃
장흥21.4℃
영주16.8℃
강릉17.1℃
정선군16.7℃
고흥21.3℃
동두천19.0℃
대구18.3℃
울릉도16.4℃
여수18.9℃
북강릉15.9℃
안동18.8℃
금산19.3℃
산청18.3℃
파주17.8℃
전주20.6℃
영천18.1℃
흑산도22.1℃
고창21.0℃
서산19.0℃
동해16.1℃
춘천14.9℃
인천17.7℃
부산20.8℃
영광군20.2℃
순천19.8℃
광주20.0℃
수원19.3℃
제주21.8℃
완도20.9℃
창원19.0℃
거제19.2℃
광양시20.1℃
임실19.6℃
양산시21.1℃
서청주17.9℃
함양군19.5℃
남해18.5℃
서울18.4℃
목포21.6℃
의성19.3℃
부여17.9℃
홍성17.9℃
군산18.4℃
밀양19.8℃
제천16.1℃
문경17.7℃
이천17.1℃
인제16.1℃
고창군21.2℃
봉화17.8℃
상주17.2℃
부안19.5℃